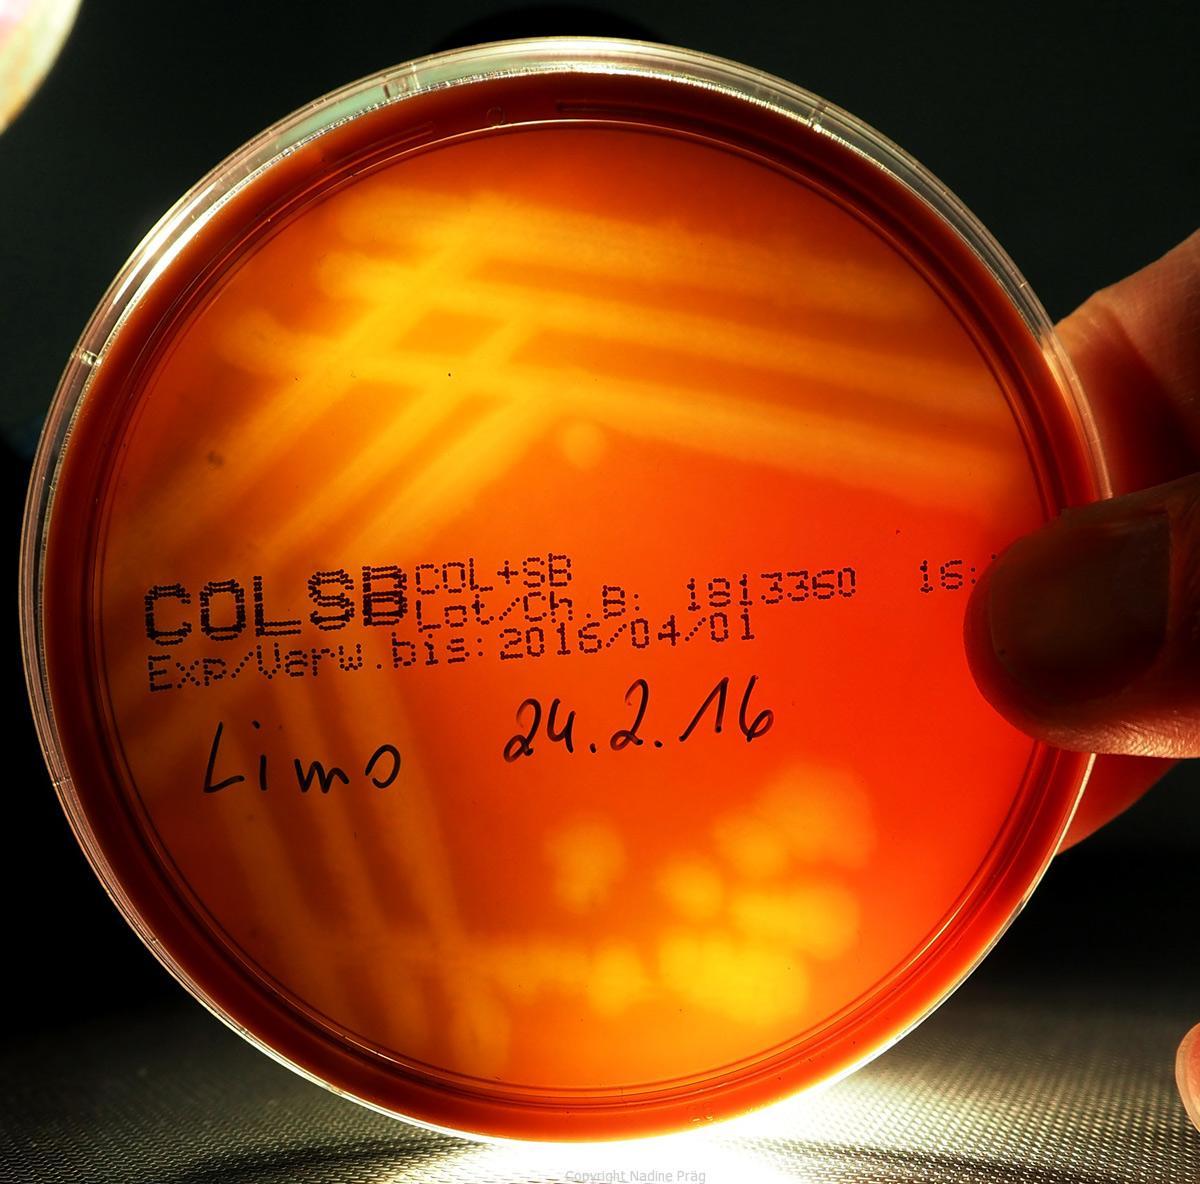
Lebensmittel Mikrobiologie I mikrobalpina

Ohne Mikroorganismen gäbe es keinen Käse! Während man bei Mikroorganismen in Kombination mit Lebensmitteln an verdorbenes Obst oder Brot denkt, sind viele Lebensmittel, von denen man es gar nicht weiß, mikrobiell hergestellt. Nur mit Hilfe von Mikroorganismen kann man Käse und Joghurt machen, Wein und Bier produzieren und Brot backen.
Wie hängt das zusammen?
Mikrobiologie
Herstellung von Lebensmitteln
Bild: Camembert, eine Bakterienkultur, Sauerkraut und Kimchi (koreanische Version des Sauerkrauts – fermentierter Chinakohl und anderes Gemüse).
Sauerkraut & Kimchi
Fermentieren von Lebensmitteln
Was Mikroorganismen auch können, ist Lebensmittel für längere Zeit zu konservieren. So entstehen zB. Sauerkraut und Kimchi – und wie nie zuvor ist das Fermentieren von Gemüse und vielem anderen derzeit weltweit sehr beliebt.
Idee/Organisation
Institut für Mikrobiologie (Nadine Präg)